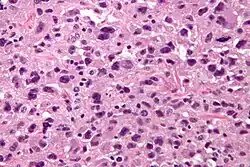
Pleomorphic undifferentiated sarcoma - very high mag

Sarcoma pleomorfo indiferenciado
| Sarcoma pleomorfo indiferenciado | ||
|---|---|---|
Sarcoma pleomorfo indiferenciado. Imagen histológica de gran aumento. Tinción de Hematoxilina-Eosina. | ||
| Especialidad | Oncología | |
| Síntomas | Masa con edema, dolor, fracturas patológicas | |
| Tratamiento | Resección quirúrgica, radioterapia, quimioterapia | |
| Frecuencia |
Prevalencia: 1-9/100 000 Incidencia: 0,8-1 nuevos casos/100 000 | |
El sarcoma pleomorfo indiferenciado (SPI) agrupa tumores mesenquimatosos malignos con células pleomorfas de alto grado que no pueden clasificarse en otra categoría mediante una combinación de histomorfología, inmunofenotipo, ultraestructura o genética molecular. A pesar de los avances en la caracterización molecular de los sarcomas, el sarcoma pleomorfo indiferenciado representa la categoría más amplia de sarcomas del adulto.[1] Esta caracterizado por una elevada recurrencia local y significativa de metástasis.[2]
Epidemiología
El sarcoma pleomórfico indiferenciado es el cuarto sarcoma de tejidos blandos más frecuente, con un ligero predominio masculino. En una serie europea se ha descrito una incidencia anual de 0,8-1 nuevos casos/100 000.[2]
Etiología
Se cree que el sarcoma pleomorfo indiferenciado deriva de células mesenquimales primitivas con capacidad de diferenciarse en histiocitos, fibroblastos, miofibroblastos y osteoclastos. La etiología tumoral sigue siendo desconocida. En algunos casos la radioterapia previa es un factor de riesgo probable.[2]
Existen grandes cambios genéticos no característicos de SPI, siendo la mayoría de estos tumores aneuploides, con varios cambios cromosómicos estructurales y numéricos.[1]
Clínica
El tumor se desarrolla con mayor frecuencia durante la sexta y séptima décadas de vida.[2] Se presenta como una masa acompañada de edema, dolor, fracturas patológicas y alteraciones sistémicas ocasionales. La mayor parte se originan en los tejidos blandos profundos de las extremidades inferiores, especialmente el muslo de adultos de edad intermedia o ancianos.[1] Otras localizaciones frecuentes son la parte superior de los brazos, el retroperitoneo, las vísceras, la cabeza y el cuello (en la infancia). El SPI óseo primario se presenta con mayor frecuencia en fémur, tibia proximal y el húmero.[2]
Tratamiento
El sarcoma pleomorfo indiferenciado debe remitirse a un centro de referencia para obtención de biopsia del tumor primario con revisión patológica experta y tratamiento multidisciplinar. El estudio histológico es necesario previo a una resección quirúrgica ya que la resección inapropiada esta asociada con un mayor riesgo de recidiva y muerte.
El tratamiento recomendado es una escisión quirúrgica amplia, a menudo, es necesaria la amputación para eliminar la lesión completa. La radioterapia adyuvante se administra en tumores profundos de alto grado, de gran tamaño (mayores de 5 cm), en cirugía conservadora y cuando los márgenes no son negativos. En el caso de sarcomas no resecables, la radioterapia primaria puede ser una opción, aunque el tratamiento de elección de primera línea para lesiones localmente irresecables y/o metastásicas suele ser quimioterapia basada en el uso de doxorrubicina.[2]
Pronóstico
El pronóstico es malo en general, con aparición de metástasis en el 30-50% de los pacientes.[1]
La tasa de supervivencia a 5 años descrita para pacientes con tumores de cabeza y cuello es del 48%, mientras que para pacientes con tumores que se originan en el tronco y las extremidades es del 77%. La variante pediátrica tiene mejor pronóstico.[2]
Morfología
Los sarcomas pleomorfos indiferenciados son, en general, masas carnosas grandes de color blanco-gris y pueden alcanzar un tamaño bastante grande (10-20 cm) según el compartimento anatómico. Es frecuente la aparición de necrosis y la hemorragia. Consisten en capas de células poligonales a fusiformes anaplásicas grandes con núcleos hipercromáticos irregulares, a veces anómalos. Las mitosis, especialmente formas atípicas asimétricas, son abundantes, igual que la necrosis coagulativa. Por definición, las células tumorales carecen de diferenciación en estirpes celulares identificables.[1]
Referencias
- ↑ a b c d e Kumar, Vinay, 1944-; Aster, Jon C. (2015). Robbins y Cotran. Patología estructural y funcional.. Elsevier Health Sciences Spain - T. ISBN 978-84-9022-879-1. OCLC 936877819. Consultado el 3 de febrero de 2021.
- ↑ a b c d e f g [https://www.orpha.net/consor/cgi-bin/OC_Exp.php?lng=ES&Expert=2023 «Orphanet: Sarcoma pleom�rfico indiferenciado»]. www.orpha.net. Consultado el 3 de febrero de 2021.